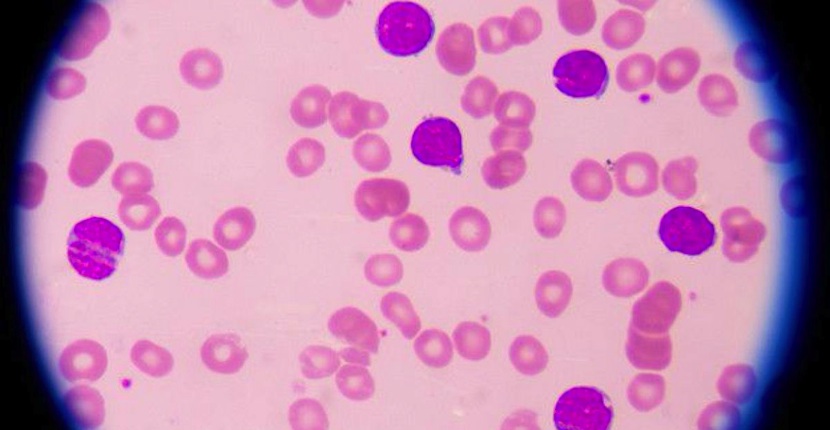
Leuko

Leuko
Links: → Visit Store → Search Google
es básicamente un dispositivo del tamaño de un teléfono móvil que literalmente es paz, gracias a un sensor equipado, de detectar y cuantificar los leucocitos en sangre de un usuario a través d ella piel. Lo que quiere decir todo esto es que estamos ante un sistema capaz, de forma no invasiva de contar los glóbulos blancos que cualquier persona tiene en un momento dado en sangre, algo que es de enorme importancia dentro del sector de la medicina.
La idea de crear Leuko fue de Carlos Castro-González, un ingeniero de León que, tal y como comenta, hace algo así como dos años él y su equipo se dieron cuenta de que sería más que interesante e incluso se podría salvar bastantes vidas y mejorar de paso determinados tratamientos, si se pudiese, de alguna forma no invasiva, llevar un seguimiento del estado de las defensas de un paciente, algo básico para así conseguir adaptar mucho mejor los tratamientos.
=> Recibir por Whatsapp las noticias destacadas
Como suele siempre ocurrir, la idea iba mucho más allá ya que lo que buscaba el equipo era directamente encontrar un sistema que permitiese a los pacientes sometidos a quimioterapia poder recibir un mejor tratamiento o al menos mucho más óptimo. La solución que se ofrecer con Leuko permite realizar en un momento dado un test sanguíneo no invasivo capaz de monitorizar con gran eficacia los glóbulos blancos en sangre de una manera muy sencilla y con frecuencia diaria.
Gracias a esto cualquier médico puede conocer en todo momento si un paciente en concreto puede recibir una dosis mayor o modificar su frecuencia, lo que puede ayudar enormemente a optimizar la terapia y mejorar la recuperación. Como no podía ser de otra manera el valor de Leuko ha sido reconocido por la comunidad médica internacional y hoy día cuenta con el apoyo del MIT, el Hospital General de Massachussets y la Universidad de Boston entre otras instituciones.
Llegados a este punto tan sólo me quedaría comentarte que hoy día el dispositivo Leuko todavía está en fase de pruebas y se están llevando a cabo estudios clínicos con pacientes reales. Gracias a los resultados obtenidos el equipo responsable del desarrollo el proyecto espera realizar suficiente mejoras con la idea de que en 2018 este dispositivo esté listo para ser comercializado.
Fuente: actualidadgadget.com